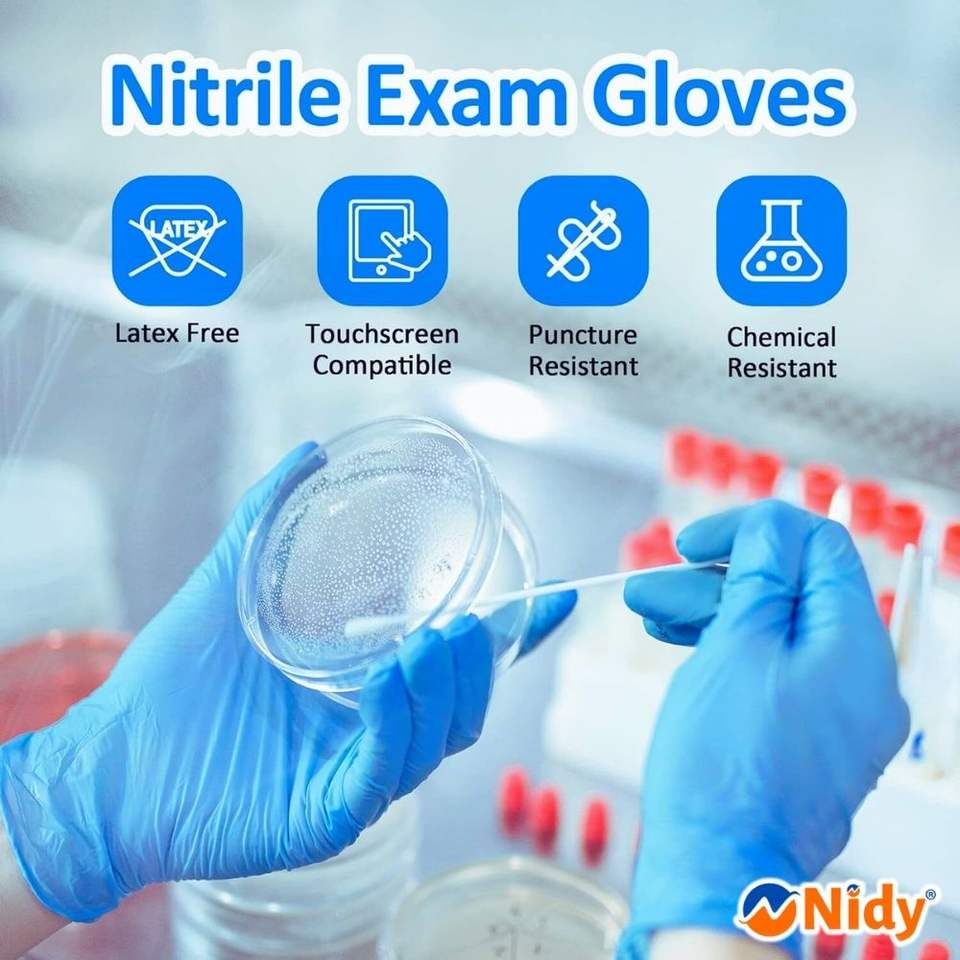

ถุงมือไนไตรล์สำหรับใช้ในโรงแรมและเดินทางถุงมือป้องกันแบบใช้แล้วทิ้งไม่มีน้ำยางปลอดภัยต่อสุขอนามัย
ยังไม่มีรีวิว

คุณลักษณะ
ผลิตภัณฑ์ดูแลผิวการประยุกต์ใช้
Disposableรูป
Nitrileวัสดุ
Glovesประเภท
กันน้ำคุณสมบัติ
Noneประเภทปลั๊ก
หมายเลขรุ่น:NW-25-NG_100-M-CT7
ชื่อแบรนด์:Nidy
สถานที่กำเนิด:Madhya Pradesh, India
OEM / ODM:Accepted
Certificate:ISO 9001:2015, ISO 13485, GMP, CE, and ZED (India)
Color:White, Black, Medical Blue, Medical Green, Pink etc.
Package:20 & 100 Pcs as Standard (Customization available)
MOQ:200 Units
SAMPLE:Free (Only Shipping to be paid)
Fabric:S, SS, SSS, Meltblown (M), SMS, SMMS, SSMMS, SMMSM, SMSM etc.
Lead Time:Fast-moving items are kept in ready stock.
Logo:Customization Possible
Usage scenarios:Fresh sheet for every guest/patient
Use time:Disposable / Single Use
Perforation and Embossing:Possible on higher MOQs
Quality:Multi-stage QC from raw material to finished product.
Style:Customization Available
คุณสมบัติที่สำคัญ
การประยุกต์ใช้
ผลิตภัณฑ์ดูแลผิว
รูป
Disposable
วัสดุ
Nitrile
ประเภท
Gloves
คุณสมบัติ
กันน้ำ
ประเภทปลั๊ก
None
หมายเลขรุ่น
NW-25-NG_100-M-CT7
ชื่อแบรนด์
Nidy
สถานที่กำเนิด
Madhya Pradesh, India
OEM / ODM
Accepted
Certificate
ISO 9001:2015, ISO 13485, GMP, CE, and ZED (India)
Color
White, Black, Medical Blue, Medical Green, Pink etc.
Package
20 & 100 Pcs as Standard (Customization available)
MOQ
200 Units
SAMPLE
Free (Only Shipping to be paid)
Fabric
S, SS, SSS, Meltblown (M), SMS, SMMS, SSMMS, SMMSM, SMSM etc.
Lead Time
Fast-moving items are kept in ready stock.
Logo
Customization Possible
Usage scenarios
Fresh sheet for every guest/patient
Use time
Disposable / Single Use
Perforation and Embossing
Possible on higher MOQs
Quality
Multi-stage QC from raw material to finished product.
Style
Customization Available
บรรจุภัณฑ์และการนำส่ง
ขายหน่วย
รายการเดียว
เดี่ยวน้ำหนักรวม
18.000 กก.
ระยะเวลารอสินค้า
คำอธิบายผลิตภัณฑ์จากซัพพลายเออร์
คำเตือน/ข้อสงวนสิทธิ์
แคลิฟอร์เนียเสนอ65เตือนผู้บริโภคดูเพิ่มเติม
1 - 2,499 ชิ้น
฿1.93
2,500 - 13,999 ชิ้น
฿1.61
>= 14,000 ชิ้น
฿1.29
รวมค่าธรรมเนียมในการนำเข้าแล้วดรอปชิปผลิตภัณฑ์นี้ไปที่ร้านค้าของคุณ







···
การคุ้มครองคำสั่งซื้อ Alibaba.com
การชำระเงินที่ปลอดภัย
ทุกการชำระเงินที่คุณทำบน Alibaba.com มีความปลอดภัยด้วยการเข้ารหัส SSL และโปรโตคอลการป้องกันข้อมูล PCI DSS ที่เข้มงวด
การคุ้มครองการคืนเงิน
รับเงินคืนหากคำสั่งซื้อไม่ถูกจัดส่ง สูญหาย หรือสินค้ามาถึงพร้อมกับปัญหาด้านคุณภาพ









